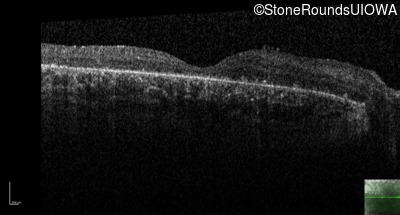

Case
SR32
Student Mode
Bardet Biedl Syndrome (IB2)
Female
Female
Hidden
SR32
Student Mode
Bardet Biedl Syndrome (IB2)
Female
Female
Highlighted Images
| Age at visit: 25 years | OD | OS |
|---|---|
History
This 25 year old woman has had reduced acuity since age 6 (20/60 OD & 20/100 OS). She had abnormal pigmentation noted in her retina at that time. She had postaxial polydactyl of the left hand and right foot.
| Age at visit: 18 years |
| OD | OS | ||
|---|---|---|---|
| Age at visit: 24 years |
| OD | OS | ||
|---|---|---|---|
| Age at visit: 28 years |
| OD | OS | ||
|---|---|---|---|
Diagnosis & molecular findings
| Disease | Gene | Allele 1 variant(s) | Allele 2 variant(s) | Inheritance mode |
|---|---|---|---|---|
| Bardet Biedl Syndrome | BBS10 | Asn222 ins6TGTTGG | Lys708 del2gttAA | AR |
Disease:
Gene:
Allele 1:
Asn222 ins6TGTTGG
Allele 2:
Lys708 del2gttAA
Inheritance:
AR